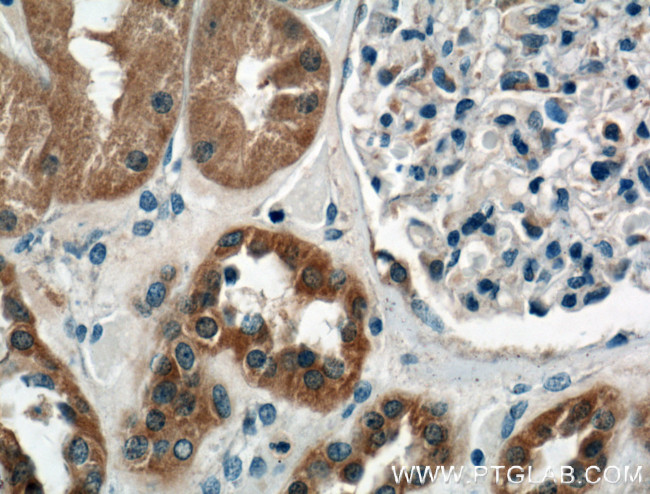
P2RX4 Antibody in Immunohistochemistry (Paraffin) (IHC (P))

Search
Proteintech
P2RX4 Monoclonal Antibody (1A5A6)
{{$productOrderCtrl.translations['antibody.pdp.commerceCard.promotion.promotions']}}
{{$productOrderCtrl.translations['antibody.pdp.commerceCard.promotion.viewpromo']}}
{{$productOrderCtrl.translations['antibody.pdp.commerceCard.promotion.promocode']}}: {{promo.promoCode}} {{promo.promoTitle}} {{promo.promoDescription}}. {{$productOrderCtrl.translations['antibody.pdp.commerceCard.promotion.learnmore']}}
产品信息
66416-1-IG
种属反应
宿主/亚型
分类
类型
克隆号
抗原
偶联物
形式
浓度
纯化类型
保存液
内含物
保存条件
运输条件
产品详细信息
Immunogen sequence: TDSVVSSVT TKVKGVAVTN TSKLGFRIWD VADYVIPAQE ENSLFVMTNV ILTMNQTQGL CPEIPDATTV CKSDASCTAG SAGTHSNGVS TGRCVAFNGS VKTCEVAAWC PVEDDTHVPQ PAFLKAAENF TLLVKNNIWY PKFNFSKRNI LPNITTTYLK SCIYDAKTDP FCPIFRLGKI VENAGHGFQD MAVEGGIMGI QVNWDCNLDR AASLCLPRYS FRRLDTRDVE HNVSPGYNFR FAKYYRDLAG NEQRTLIKAY GIRFDIIVFG KAGKFDIIPT MINIGS (57-341 aa encoded by BC033826)
靶标信息
The product of this gene belongs to the family of purinoceptors for ATP. This receptor functions as a ligand-gated ion channel with high calcium permeability. The main pharmacological distinction between the members of the purinoceptor family is the relative sensitivity to the antagonists suramin and PPADS. The product of this gene has the lowest sensitivity for these antagonists. Multiple alternatively spliced transcript variants have been identified for this gene although their full-length natures have not been determined.
仅用于科研。不用于诊断过程。未经明确授权不得转售。
生物信息学
蛋白别名: ATP receptor; ATP-gated cation channel protein; ionotropic purinergic receptor; P2X purinoceptor 4; P2X receptor, subunit 4; P2X4; Purinergic receptor; purinergic receptor P2X, ligand gated ion channel, 4; purinergic receptor P2X, ligand-gated ion channel, 4; purinergic receptor P2X4; purinergic receptor P2x4 subunit variant e; purinoceptor P2X4
基因别名: AI504491; AW555605; D5Ertd444e; P2RX4; P2X4; P2X4R
UniProt ID: (Human) Q99571, (Rat) P51577
Entrez Gene ID: (Pig) 100157723, (Human) 5025, (Mouse) 18438, (Rat) 29659